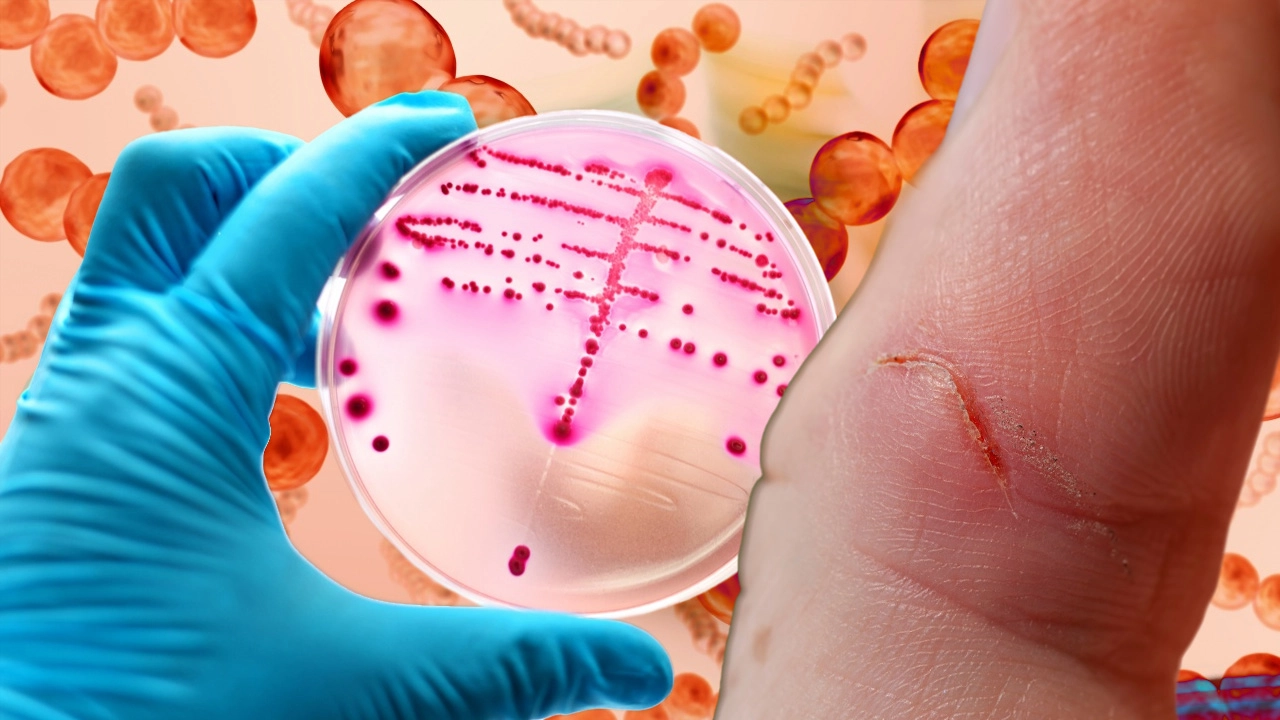
เป็นแผล เสี่ยงโรคแบคทีเรียกินเนื้อ ระบาดหนักในญี่ปุ่น ไม่ตายก็ตัดแขนขา

โอกาสโรคแบคทีเรียกินเนื้อจะระบาดในไทย มีมากน้อยแค่ไหน หลังระบาดรุนแรงในญี่ปุ่นในอัตราที่สูงมากเป็นประวัติการณ์ โดยปีที่แล้วมีคนติดเชื้อ 941 ราย และช่วง 2 เดือนแรกของปีนี้เพิ่มขึ้นอย่างรวดเร็ว มีคนติดเชื้อไปแล้ว 378 ราย และผู้มีอายุต่ำกว่า 50 ปีเสียชีวิตมากขึ้น จนเกิดความกังวลว่าโรคแบคทีเรียกินเนื้อ จะเล็ดลอดเข้ามาระบาดในไทยหรือไม่ เพราะญี่ปุ่นเป็นจุดหมายปลายทางที่คนไทยเข้ามาท่องเที่ยวเป็นจำนวนมาก

อีกทั้งผู้เชี่ยวชาญเผยแพร่ในวารสารการแพทย์ JAMA ออนไลน์ เมื่อ 10 ม.ค. 2567 เชื่อว่าโรคแบคทีเรียกินเนื้อ และการระบาดของโรคทางเดินหายใจอื่นๆ อาจเชื่อมโยงเกี่ยวข้องกับโควิด จากมาตรการป้องกันการแพร่เชื้อของโควิด ทำให้ร่างกายขาดการสัมผัสกับเชื้อโรคทั่วไป จนภูมิคุ้มกันในร่างกายเกิดช่องโหว่อ่อนแอลงโดยเฉพาะในเด็ก ที่เรียกว่า “หนี้ภูมิคุ้มกัน” (immunity debt) หรือผู้เคยติดเชื้อโควิด อาจส่งผลกระทบต่อระบบภูมิคุ้มกันที่เรียกว่า “ขโมยภูมิคุ้มกัน” (immunity theft) มีความเสี่ยงสูงจะติดเชื้อโรคอื่นๆ
...

แนวคิดหนี้ภูมิคุ้มกัน ทำให้เกิดโรคติดเชื้อในระยะหลัง มีหลักฐานสนับสนุนมากกว่า จากการระบาดของโรคติดเชื้อในปอดในเด็กทั่วโลกช่วงปลายปี 2566 หลังยกเลิกมาตรการควบคุมโควิด รวมถึงการระบาดของเชื้อไวรัส RSV ในสหรัฐฯ และออสเตรเลีย ก่อโรคระบบทางเดินหายใจโดยเฉพาะเด็กเล็ก และเชื้อไมโคพลาสมา (mycoplasma pneumoniae) ระบาดในจีน เป็นเชื้อแบคทีเรียขนาดเล็กก่อให้เกิดโรคระบบทางเดินหายใจ กระท่ังล่าสุดในญี่ปุ่นเกิดการระบาดของโรคแบคทีเรียกินเนื้อ ซึ่งยังไม่สามารถระบุสาเหตุได้
เป็นแผล ระวังติดเชื้อแบคทีเรียกินเนื้อ ลุกลามถูกตัดแขนขา
โรคแบคทีเรียกินเนื้อ หรือโรคกินเนื้อ แพร่กระจายผ่านละอองฝอยและการสัมผัส เช่นเดียวกับโควิด และสามารถแพร่เชื้อผ่านบาดแผลที่มือและเท้าของผู้ป่วย โดยผู้ติดเชื้ออาจได้รับผลกระทบรุนแรงจนเนื้อเยื่อเกี่ยวพันที่แทรกอยู่ในร่างกาย ช่วยพยุงยึดเหนี่ยวอวัยวะให้คงรูป อาจเกิดการตายเฉพาะที่ จากการติดเชื้อและพิษของเชื้อแบคทีเรีย จนส่งผลให้เนื้อเยื่อและกล้ามเนื้อเน่าตาย จะต้องผ่าตัดเอาเนื้อเยื่อส่วนที่เสียหายออกไป และอาจตัดอวัยวะบางส่วน ป้องกันการลุกลาม

ผู้ติดเชื้อโรคแบคทีเรียกินเนื้อ เริ่มต้นด้วยอาการเป็นไข้ หนาวสั่น ปวดกล้ามเนื้อ คลื่นไส้และอาเจียน ซึ่งปกติใช้เวลาประมาณ 24 ถึง 48 ชั่วโมง หากอาการรุนแรงความดันโลหิตจะต่ำ หัวใจเต้นเร็ว หรือการทำงานของอวัยวะร่างกายล้มเหลว แม้เป็นโรคที่พบได้น้อย แต่มีความรุนแรง อัตราการเสียชีวิตประมาณ 30-80% ควรรีบไปพบแพทย์โดยเร็วที่สุด ในการรักษาด้วยยาปฏิชีวนะ เพื่อป้องกันโรคแทรกซ้อน ลดความเสี่ยงในการเสียชีวิตและแขนขาถูกตัด
โรคแบคทีเรียกินเนื้อ ไม่มีวัคซีนป้องกัน แต่สามารถปกป้องตัวเองและผู้อื่น ด้วยการล้างมือบ่อยๆ กินร้อนช้อนกลาง หากมีบาดแผลให้รีบล้างน้ำ ก่อนปิดแผลด้วยผ้าพันแผลที่สะอาด จนกว่าแผลจะแห้ง และหลีกเลี่ยงการแช่น้ำร้อน ว่ายน้ำในสระ หรือเล่นน้ำในแหล่งธรรมชาติ และหลีกเลี่ยงการสัมผัสกับผู้ติดเชื้อ หรือมีความเสี่ยงใกล้ชิดกับผู้ติดเชื้อ ต้องรับประทานยาปฏิชีวนะ หากแพทย์สั่ง

...
โรคแบคทีเรียกินเนื้อ เล็ดลอดระบาดในไทย ยากมาก
“ศ.เกียรติคุณ ดร.วสันต์ จันทราทิตย์” หัวหน้าศูนย์จีโนมทางการแพทย์ คณะแพทยศาสตร์ โรงพยาบาลรามาธิบดี มหาวิทยาลัยมหิดล กล่าวว่า แม้คนไทยนิยมไปเที่ยวญี่ปุ่น ซึ่งมีการระบาดของโรคแบคทีเรียกินเนื้อ แต่ไม่ต้องกังวลว่าจะเล็ดลอดเข้ามาระบาดในไทย มีโอกาสน้อยมาก เพราะโรคนี้ติดต่อเฉพาะคนที่มีภูมิคุ้มกันบกพร่อง ไม่ใช่โรคติดต่อเหมือนโควิด ทำให้มีโอกาสติดต่อได้ยากมากในไทย และกว่า 50% มักเกิดจากการติดเชื้อที่บาดแผล เช่น บาดแผลเปิดจากของมีคม หรือแก้วบาดที่ขา และคนที่เป็นงูสวัด เป็นอีสุกอีใส จึงไม่ควรลงไปแช่น้ำร้อน น้ำแร่ เล่นน้ำในสระ และในบ่อธรรมชาติ

“คนที่เสี่ยงติดโรคแบคทีเรียกินเนื้อ ส่วนใหญ่มีภูมิคุ้มกันบกพร่อง น่าจะเป็นภูมิคุ้มกันที่ไม่ค่อยสมประกอบ จากการสวมหน้ากากอนามัยนานเกินไปในช่วงโควิด จนขาดการสัมผัสกับเชื้อโรค ทำให้ภูมิคุ้มกันในร่างกายน้อยลง หรือเรียกว่าหนี้ภูมิคุ้มกัน และโรคนี้ไม่ใช่โรคอุบัติใหม่ ก็คือโรคอีดำอีแดง เป็นโรคโบราณกลับมาอีก เช่นเดียวกับโรคอื่นๆ สามารถป้องกันได้ด้วยตัวเองเหมือนการป้องกันโควิด”
...

อีกทั้งโรคแบคทีเรียกินเนื้อ มีความสามารถในการแพร่เชื้อได้น้อยมาก แตกต่างจากโควิดกระจายเชื้อได้กว้างมาก ยกเว้นมีบาดแผล จะต้องระมัดระวังในการป้องกันตัวเอง หรือกรณีคนไทยไปเที่ยวญี่ปุ่นแล้วมีบาดแผล ต้องระวังไม่ควรลงไปแช่ออนเซน แช่บ่อน้ำพุร้อน อย่างชาวนาก็ต้องระวังโรคไข้ดิน เป็นโรคติดเชื้อจากแบคทีเรีย หากคนไทยกลับมาจากเที่ยวญี่ปุ่น มีอาการคล้ายกับติดเชื้อแบคทีเรียกินเนื้อ ก็รีบไปพบแพทย์โดยเร็ว ในการรักษาด้วยยาปฏิชีวนะ และหากมีแผล ก็เอาเนื้อเยื่อไปตรวจสอบได้ จึงไม่น่ากังวลว่าโรคนี้จะระบาดในไทย